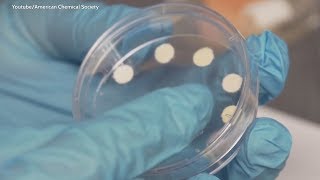

Change of color in polymer paper based sensor strip video
Online izle ve mp4 mp3 formatlarinda yukle

Videonun muddeti: 0:28
Change of color in polymer paper based sensor strip videosu mp4 ve mp3 yuklemek ucun hazirdir
Diqqet! Siz Mp4 yukle ve ya Mp3 yukle duymesine basdiqdan sonra eger sistem sizi reklam sehifesine atarsa o zaman derhal geri qayidib emeliyyati tekrar edin ve faylin yuklemek ucun hazir olmasini gozleyin
Videodan Mp4 Yukle
Videodan Mp3 Yukle-1
Videodan Mp3 Yukle-2
Oxshar Axtarishlar
 Change of color in polymer paper-based sensor strip
Change of color in polymer paper-based sensor strip Paper based temperature sensor
Paper based temperature sensor Color intensity measurement of paper-based sensor
Color intensity measurement of paper-based sensor Paper Based Sensor Tell You When Your Food Goes Bad
Paper Based Sensor Tell You When Your Food Goes Bad A Paper-Based Sensor for Monitoring Sun Exposure
A Paper-Based Sensor for Monitoring Sun Exposure MSBT's Paper-based detection device for spoiled milk
MSBT's Paper-based detection device for spoiled milk Disposable, Paper-based Sensors for Detecting Leaks
Disposable, Paper-based Sensors for Detecting Leaks Conductive polymer-based bioelectronic sensor
Conductive polymer-based bioelectronic sensor Scanning a paper-based antioxidant sensor.
Scanning a paper-based antioxidant sensor.
Video Mp4 Mp3Azwap.Biz
Azwap.Biz 2021-2023


 Change of color in polymer paper-based sensor strip
Change of color in polymer paper-based sensor strip Paper based temperature sensor
Paper based temperature sensor Color intensity measurement of paper-based sensor
Color intensity measurement of paper-based sensor Paper Based Sensor Tell You When Your Food Goes Bad
Paper Based Sensor Tell You When Your Food Goes Bad A Paper-Based Sensor for Monitoring Sun Exposure
A Paper-Based Sensor for Monitoring Sun Exposure MSBT's Paper-based detection device for spoiled milk
MSBT's Paper-based detection device for spoiled milk Disposable, Paper-based Sensors for Detecting Leaks
Disposable, Paper-based Sensors for Detecting Leaks Conductive polymer-based bioelectronic sensor
Conductive polymer-based bioelectronic sensor Scanning a paper-based antioxidant sensor.
Scanning a paper-based antioxidant sensor.